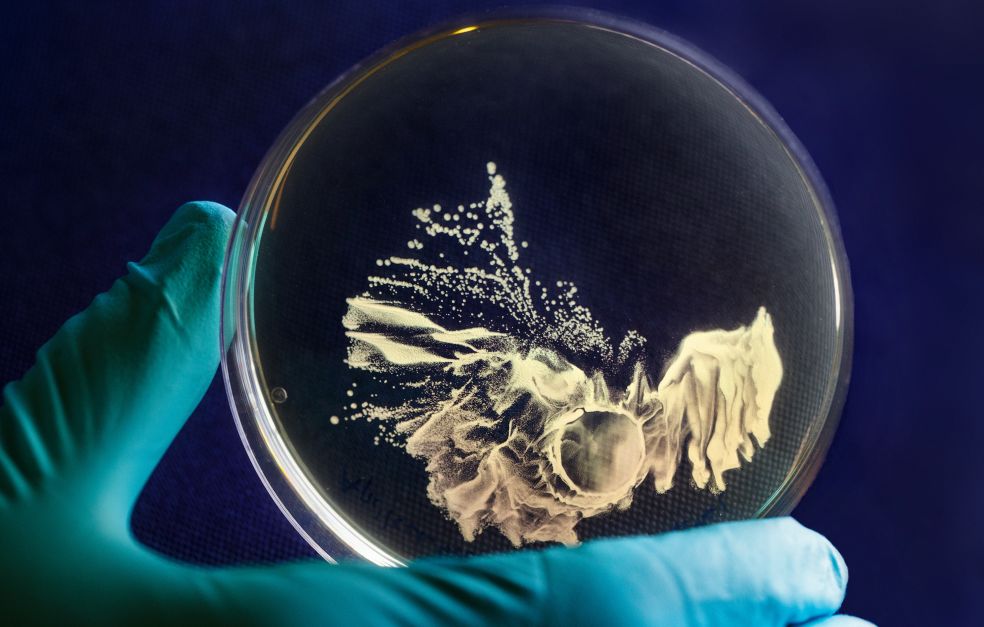

Вчена Алеандра Андерссон з Лундського університету (Швеція) провела серію досліджень бактерій, що мешкають у травній системі медоносної бджоли – зокрема, у медовому зобику та кишечнику. Раніше вважалося, що медовий зобик потрібен бджолі лише для транспортування нектару з квітки до вулика, а його мікрофлора не відіграє суттєвої ролі. Бактерії в ньому просто “пасажири”. Проте нове дослідження довело протилежне.
У ході генетичного аналізу Андерссон виявила, що частина молочнокислих бактерій, які живуть у бджолі, здатна виробляти антимікробні пептиди – короткі білкові молекули, що знищують або пригнічують ріст шкідливих мікроорганізмів, наприклад, збудників гнильцю. Тобто ці бактерії виробляють природний «антибіотик». Більше того, з’ясувалося, що такі бактерії можуть обмінюватися ділянками ДНК одна з одною. До цих ділянок належать і гени, відповідальні за синтез захисних пептидів. Завдяки цьому бактерії фактично об’єднуються в спільне «генетичне співтовариство» та здатні швидко пристосовуватись до нових загроз. Це особливо важливо у вулику, де бджоли постійно стикаються з патогенами – від грибків до вірусів.
Таким чином, бактерії у кишечнику та зобику відіграють ключову роль в імунній системі бджоли. Вчені вже підтвердили, що різноманітний і збалансований мікробіом (сукупність бактерій) робить бджіл стійкішими до інфекцій і стресу.
Наразі команда Андерссон продовжує дослідження: у лабораторії вони створюють генетичні моделі й досліджують, як саме мікроби передають захисні функції.
Природа продовжує дивувати…

Квітка Ophrys apifera (рослини, яку в народі називають “бджолина орхідея”) – формою, текстурою та забарвленням напрочуд точно імітує самку бджоли Eucera longicornis. Це маскарадне вбрання – маленьке диво еволюції, відшліфоване протягом тисячоліть. Воно гарантує, що самець не пролетить повз. Обманутий виглядом, він неодмінно збуджується, сідає на квітку з наміром спаритись, і його тільце торкається пилкових мішечків. Відлетівши та побачивши нову “красуню”, він знову намагається виконати свій “подружній обов’язок”, тим самим переносячи пилок з однієї рослини на іншу.
Чи усвідомлює він, що став жертвою обману? Швидше за все, ні. Як стверджують учені, він навіть відчуває своєрідне чоловіче задоволення, радіє від розмаїття жіночої вроди, почуваючись, мабуть, як султан у гаремі.
Але зваблювати формами підступній орхідеї замало. Аби запилення точно відбулося, хитра рослина виділяє феромони, які досконало імітують запах самки.

У регіонах, де Eucera або не мешкає, або трапляється рідко, орхідея вдається до плану Б: вона поступово згинає свої пиляки так, щоб їхні кінчики торкнулись рильця тієї ж самої квітки, здійснюючи самозапилення й гарантуючи продовження роду.
Дослідники вважають, що цей механізм самозапліднення відносно недавня адаптація, зумовлена зменшенням кількості природних запилювачів. Така стратегія має істотний недолік: вона знижує генетичну різноманітність і робить рослину більш вразливою до хвороб і менш стійкою до кліматичних викликів.
А. Гурман, тг канал Пасіка день за днем

